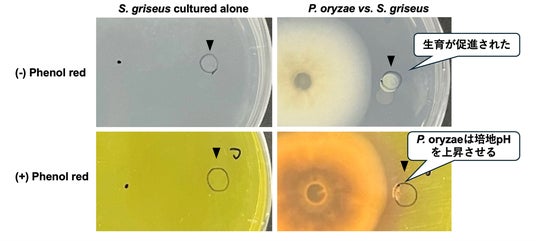

東京理科大、イネいもち病菌と放線菌の相互作用を明らかに、新たな防除法開発に期待
東京理科大学大学院創域理工学研究科生命生物科学専攻の杉浦梨紗氏、同大学創域理工学部生命生物科学科の倉持幸司教授、古山祐貴助教らの研究グループは、イネいもち病菌が不揮発性のポリアミンの産生を通じて培地のpHを上昇させ、放線菌の1種であるS. griseusの増殖を促進することを明らかにした。
微生物間の相互作用をより詳細に紐解いていくことで、生物間相互作用を利用した新たなイネいもち病菌の防除法開発につながる可能性があるという。
真菌や細菌などの微生物は、自然環境下では互いに影響し合いながら、複雑な生態系を形成している。しかし、従来の微生物学はターゲットとする1種の微生物を分離して単独で培養する手法が中心であったため、自然な状態での微生物群集のふるまいについては詳しく知られていないという。
微生物のふるまいは、近くにいる生物との相互作用に大きく左右される。そのため、有用微生物の潜在能力を十分に引き出したり、病原体を制御したりする効率的な方法を開発するためには、自然環境における、さまざまな微生物間の分子レベルでの相互作用を解明する必要がある。
イネいもち病菌は、イネの壊滅的な病気を引き起こす病原真菌だ。空気中に浮遊する胞子を通じて感染することが知られており、感染行動に焦点を当てた知見は多く蓄積している。しかし、自然環境における生態は十分に研究されておらず、防除のためには詳細な生態を理解する必要があった。
そこで同研究チームは、イネいもち病菌と他の微生物との相互作用を解明することを目指し、土壌に生息するStreptomyces属細菌の1種である「S. griseus」に着目した。Streptomyces属細菌は、放線菌と呼ばれ、主にシクロヘキシミドなどの抗生物質を含む二次代謝産物を生産することが知られている。
Streptomyces属細菌をイネいもち病菌と同時にイネに接種すると、イネいもち病の発病を抑制できる可能性が報告されているが、その相互作用の基礎となる分子メカニズムはまだはっきりと解明されていないという。
同研究グループは、これまでにイネいもち病菌がS. griseusの生育を阻害する二次代謝産物を生産することを報告している。しかし、イネいもち病菌とS. griseusが産生する二次代謝産物の種類は多岐にわたることから、実際にはこの2種の間にさらに複雑な相互作用があることが予想されていた。
以上のことから、実験室環境においてこれら2種の相互作用のメカニズムを明らかにすることを目的として研究が行われた。
Pyricularia oryzaeは接触を介さずにStreptomyces griseusの生育を促進させる。単独培養時にはS. griseusはこの条件では増殖しないが(左)、P. oryzaeと共培養を行うと生育が促進された(右)。pH指示試薬を用いた解析により、P. oryzaeがアルカリ性の代謝産物を産生することで培地のpHが上昇し、その結果S. griseusの生育が促進されていることが示唆された
研究では、イネいもち病菌およびS. griseusを、ポテトデキストロース寒天(PDA)上で培養し、相互作用を観察。その結果、S. griseus単独で培養しても増殖は確認されなかったが、イネいもち病菌と共培養することにより放線菌の増殖が促進された。
この増殖促進効果は、イネいもち病菌と放線菌が物理的に接触する前から観察され、2種の微生物の間に存在する寒天培地を切り離した場合には観察されなかったという。これらの結果は、イネいもち病菌が産生する化学物質が培地中を拡散し、S. griseusの増殖を促進していることを示唆している。
これは、本研究グループが過去に発表した「イネいもち病菌はS. griseusの生育を阻害する物質を産生する」という報告と矛盾するような結果となっている。しかし、今回の研究でイネいもち病菌と物理的に接触する前からS. griseusの増殖が見られたことから、以下2つのメカニズムが働いていると推測される。
さらに、過去の研究では、S. griseusの抗生物質はイネいもち病菌の二次代謝産物の生産を誘導することもわかっている。
これらを総合すると、イネいもち病菌とS. griseusは共通の生態的地位を共有し、競争関係を維持している可能性があると考えられる。生態的地位とは、生物種が生態系の中で占める位置、つまり食物や生息場所のことで、異なる生物種の生態的地位が一致した場合、お互いの種の存続のために相互作用が生じる。このことから、S. griseusがイネいもち病の新たな生物防除の方法として応用できる可能性があることがわかる。
次に、pH測定用指示薬であるフェノールレッドを培地に添加して、イネいもち病菌およびS. griseusのふるまいと培地のpHの関係を調べた。その結果、イネいもち病菌を囲む領域でpHの上昇が確認され、pHが上昇した領域においてS. griseusの増殖が促進されていることがわかった。
以上のことから、イネいもち病菌が産生する不揮発性のアルカリ性化合物が、S. griseusの増殖促進に関与していることが予想されている。一方で、土壌性の植物病原菌Fusarium oxysporumや昆虫の病原真菌Cordyceps tenuipesとの共培養では、S. griseusの増殖は促進されなかった。
最後に、S. griseusの増殖を促進するイネいもち病菌由来の化合物の同定を試みたという。植物病原性糸状菌の中には増殖中にアンモニアを産生し、環境のpHが上昇させる能力を有する株が存在することが報告されているため、まずはS. griseusの増殖が誘導された培地からアンモニアが検出できるのかを調べた。
しかし、予想に反してアンモニアは検出されず、S. griseusの増殖促進には他の物質が関わっていることが示唆された。そこで研究グループは、ポリアミン生合成阻害剤であるDL-α-ジフルオロメチルオルニチンを培地に添加したところ、イネいもち病菌によるpH上昇およびS. griseusの増殖促進が阻害されたという。
これにより、イネいもち病菌はポリアミンを産生することで、周囲のpHを上昇させていることが示唆された。
古山助教のコメント
今回の発見を基礎として、微生物間の相互作用をより詳細に紐解いていくことで、生物間相互作用を利用した新たなイネいもち病菌の防除法開発につながる可能性があるとしている。
論文情報
雑誌名:Environmental Microbiology Reports
論文タイトル:Pyricularia oryzae enhances Streptomyces griseus growth via non-volatile alkaline metabolites
著者:Risa Sugiura, Takayuki Arazoe, Takayuki Motoyama, Hiroyuki Osada, Takashi Kamakura, Kouji Kuramochi, Yuuki Furuyama
DOI:10.1111/1758-2229.70012
URL:https://enviromicro-journals.onlinelibrary.wiley.com/doi/10.1111/1758-2229.70012
東京理科大学
https://www.tus.ac.jp/
微生物間の相互作用をより詳細に紐解いていくことで、生物間相互作用を利用した新たなイネいもち病菌の防除法開発につながる可能性があるという。
イネいもち病菌の新たな防除法開発に期待
真菌や細菌などの微生物は、自然環境下では互いに影響し合いながら、複雑な生態系を形成している。しかし、従来の微生物学はターゲットとする1種の微生物を分離して単独で培養する手法が中心であったため、自然な状態での微生物群集のふるまいについては詳しく知られていないという。
微生物のふるまいは、近くにいる生物との相互作用に大きく左右される。そのため、有用微生物の潜在能力を十分に引き出したり、病原体を制御したりする効率的な方法を開発するためには、自然環境における、さまざまな微生物間の分子レベルでの相互作用を解明する必要がある。
イネいもち病菌は、イネの壊滅的な病気を引き起こす病原真菌だ。空気中に浮遊する胞子を通じて感染することが知られており、感染行動に焦点を当てた知見は多く蓄積している。しかし、自然環境における生態は十分に研究されておらず、防除のためには詳細な生態を理解する必要があった。
そこで同研究チームは、イネいもち病菌と他の微生物との相互作用を解明することを目指し、土壌に生息するStreptomyces属細菌の1種である「S. griseus」に着目した。Streptomyces属細菌は、放線菌と呼ばれ、主にシクロヘキシミドなどの抗生物質を含む二次代謝産物を生産することが知られている。
Streptomyces属細菌をイネいもち病菌と同時にイネに接種すると、イネいもち病の発病を抑制できる可能性が報告されているが、その相互作用の基礎となる分子メカニズムはまだはっきりと解明されていないという。
同研究グループは、これまでにイネいもち病菌がS. griseusの生育を阻害する二次代謝産物を生産することを報告している。しかし、イネいもち病菌とS. griseusが産生する二次代謝産物の種類は多岐にわたることから、実際にはこの2種の間にさらに複雑な相互作用があることが予想されていた。
以上のことから、実験室環境においてこれら2種の相互作用のメカニズムを明らかにすることを目的として研究が行われた。
研究では、イネいもち病菌およびS. griseusを、ポテトデキストロース寒天(PDA)上で培養し、相互作用を観察。その結果、S. griseus単独で培養しても増殖は確認されなかったが、イネいもち病菌と共培養することにより放線菌の増殖が促進された。
この増殖促進効果は、イネいもち病菌と放線菌が物理的に接触する前から観察され、2種の微生物の間に存在する寒天培地を切り離した場合には観察されなかったという。これらの結果は、イネいもち病菌が産生する化学物質が培地中を拡散し、S. griseusの増殖を促進していることを示唆している。
これは、本研究グループが過去に発表した「イネいもち病菌はS. griseusの生育を阻害する物質を産生する」という報告と矛盾するような結果となっている。しかし、今回の研究でイネいもち病菌と物理的に接触する前からS. griseusの増殖が見られたことから、以下2つのメカニズムが働いていると推測される。
1. S. griseusは接触前にイネいもち病菌の存在を検出することができる
2. S. griseusはイネいもち病菌に対抗するのに十分な量の抗生物質を産生するため盛んに増殖する
2. S. griseusはイネいもち病菌に対抗するのに十分な量の抗生物質を産生するため盛んに増殖する
さらに、過去の研究では、S. griseusの抗生物質はイネいもち病菌の二次代謝産物の生産を誘導することもわかっている。
これらを総合すると、イネいもち病菌とS. griseusは共通の生態的地位を共有し、競争関係を維持している可能性があると考えられる。生態的地位とは、生物種が生態系の中で占める位置、つまり食物や生息場所のことで、異なる生物種の生態的地位が一致した場合、お互いの種の存続のために相互作用が生じる。このことから、S. griseusがイネいもち病の新たな生物防除の方法として応用できる可能性があることがわかる。
次に、pH測定用指示薬であるフェノールレッドを培地に添加して、イネいもち病菌およびS. griseusのふるまいと培地のpHの関係を調べた。その結果、イネいもち病菌を囲む領域でpHの上昇が確認され、pHが上昇した領域においてS. griseusの増殖が促進されていることがわかった。
以上のことから、イネいもち病菌が産生する不揮発性のアルカリ性化合物が、S. griseusの増殖促進に関与していることが予想されている。一方で、土壌性の植物病原菌Fusarium oxysporumや昆虫の病原真菌Cordyceps tenuipesとの共培養では、S. griseusの増殖は促進されなかった。
最後に、S. griseusの増殖を促進するイネいもち病菌由来の化合物の同定を試みたという。植物病原性糸状菌の中には増殖中にアンモニアを産生し、環境のpHが上昇させる能力を有する株が存在することが報告されているため、まずはS. griseusの増殖が誘導された培地からアンモニアが検出できるのかを調べた。
しかし、予想に反してアンモニアは検出されず、S. griseusの増殖促進には他の物質が関わっていることが示唆された。そこで研究グループは、ポリアミン生合成阻害剤であるDL-α-ジフルオロメチルオルニチンを培地に添加したところ、イネいもち病菌によるpH上昇およびS. griseusの増殖促進が阻害されたという。
これにより、イネいもち病菌はポリアミンを産生することで、周囲のpHを上昇させていることが示唆された。
古山助教のコメント
イネいもち病菌はイネに甚大な被害を与える重要植物病害菌ですが、その生活環の全貌は明らかになっていません。今回、実験室レベルではありますが、土壌性の微生物との新たな相互作用関係を見出すことができたことは大変意義深いです。
今回の発見を基礎として、微生物間の相互作用をより詳細に紐解いていくことで、生物間相互作用を利用した新たなイネいもち病菌の防除法開発につながる可能性があるとしている。
論文情報
雑誌名:Environmental Microbiology Reports
論文タイトル:Pyricularia oryzae enhances Streptomyces griseus growth via non-volatile alkaline metabolites
著者:Risa Sugiura, Takayuki Arazoe, Takayuki Motoyama, Hiroyuki Osada, Takashi Kamakura, Kouji Kuramochi, Yuuki Furuyama
DOI:10.1111/1758-2229.70012
URL:https://enviromicro-journals.onlinelibrary.wiley.com/doi/10.1111/1758-2229.70012
東京理科大学
https://www.tus.ac.jp/
SHARE